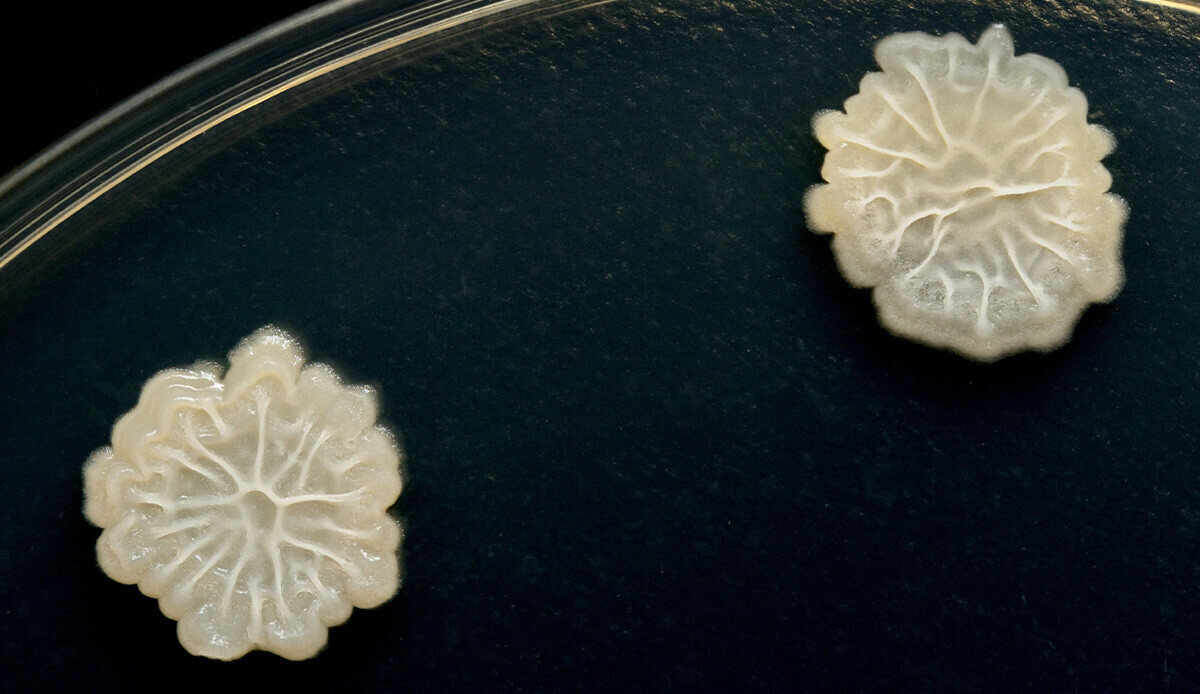
Kimsenin aklına gelmeyecek tehlike… Mikrop saçıyor, koşup hemen kaldırın

Kimsenin aklına gelmeyecek tehlike… Mikrop saçıyor, koşup hemen kaldırın
Çoğumuz yıllardır diş fırçasını ayna önünde veya lavabonun hemen yanında saklıyoruz. Oysa banyoda sifonu çektiğimizde havaya karışan bakteriler fırçaya bulaşabiliyor. Diş fırçanız klozete yakınsa dikkat!
Dişlerinizi banyoda fırçaladığınıza göre, diş fırçanızı da orada tutmak mantıklı geliyor değil mi? Uzmanlar açısından öyle değil. Peki, ama neden?
Daily Star’da yer alan bir haberde, diş fırçanızı banyoda tutmanın sakıncası paylaşıldı. Banyonuzdaki eşyalarınızı temiz tuttuğunuzu düşünseniz de sifonu her çektiğinizde bakteriler yayılıyor.
Evet, kulağa geldiği kadar kötü bir durum; çünkü klozetteki mikroplar etrafa kolayca yayılabilir. Bunun anlamı, her sifonu çektiğinizde diş fırçanıza idrar damlacıklarının bulaşması anlamına gelebilir.
KLOZET KAPAĞINIZ KAPALI OLSUN
Uzmanlar, görünmez dışkı parçacıklarının her yere sıçramasını önlemek için klozet kapağınızı aşağı indirmenizi ve o şekilde sifonu çekmenizi tavsiye ediyor. Ayrıca diş fırçanızı yatak odanız gibi başka bir yerde tutmanız tavsiye ediliyor.
Gönül rahatlığıyla kullanmak için bir diş fırçası kılıfı da alabilirsiniz. Diş hekimi Jessica O'Connor, ev halkından her bireyin kendi çıkarılabilir başlığına sahip bir elektrikli diş fırçasının edinmesi gerektiğinin belirtiyor.
BU HATAYA DİKKAT!
CNN’de yer alan bir haberde ise dişleri yanlış fırçalamanın zararları ise şu şekilde aktarılıyor:
-Yapılan en yaygın hatalardan birisi dişleri yanlış fırçalamaktır. Bu, en yaygın hatalardan biridir. Dişlerinizi, diş etinizden diş etinize doğru yalnızca aşağı hareketler yaparak, baskı uygulamadan fırçalayın. Aksi halde farkında olmadan zarar verebilirsiniz.
-Ayrıca dişlerinizin sadece görünen yüzeylerini değil, göremediğiniz görünmeyen yüzeylerini ve diş etlerinin başlangıç noktalarını da fırçalamaya özen gösterin. Bakterilerden kurtulmak için dilinizi fırçalamayı unutmayın.



















